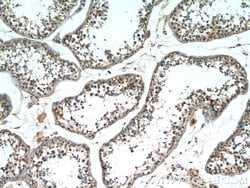
SCML2 Rabbit anti-Human, Mouse, Polyclonal, Proteintech 150 &mu;L | Buy Online | Proteintech | Fisher Scientific

missing translation for 'onlineSavingsMsg'
Learn More
Learn More
Description
SCML2 is a putative component of a Polycomb group (PcG) multiprotein complex involved in represing transcription of homeotic genes during development. It mediates chromatin remodeling and DNA dependent negative regulation of transcription by binding to methylated lysine residues in histone tails.
Spécification
Spécification
| Antigène | SCML2 |
| Applications | Immunocytochemistry, Immunofluorescence, Immunohistochemistry (Paraffin), Immunoprecipitation, Western Blot |
| Classification | Polyclonal |
| Concentration | 0.48 mg/mL |
| Conjugué | Unconjugated |
| Formule | PBS with 50% glycerol and 0.1% sodium azide; pH 7.3 |
| Expression | SCML2 |
| Numéro d’ordre du gène | Q9UQR0 |
| Alias de gène | SCML2 |
| Symboles de gène(s) | SCML2 |
| Afficher plus |
Nom du produit
En cliquant sur Soumettre, vous reconnaissez que vous pouvez être contacté par Fisher Scientific au sujet des informations que vous avez fournies dans ce formulaire. Nous ne partagerons pas vos informations à d'autres fins. Toutes les informations de contact fournies seront également conservées conformément à notre politique de confidentialité. Politique de confidentialité.
Vous avez repéré une opportunité d'amélioration ?